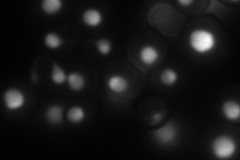
YPR112C

View description
Essential conserved protein that is part of the 90S preribosome; required for production of 18S rRNA and small ribosomal subunit; contains five consensus RNA-binding domains
Localization:
Intensity:
Fold change:
Significance:
-
C’ GFP library in SD

below threshold16.69 -
N' NOP1pr-GFP in SD
nucleolus99.0874 -
N' TEF2pr-mCherry in SD

nucleus109.105 -
N' NATIVEpr-GFP in SD

nucleus,nucleolus88.8342 -
N' TEF2pr-VC and Cyto-VN in SD

nucleus44.8371 -
C’ GFP library in SD+DTT

cytosol17.461.04No -
C’ GFP library in SD+H2O2

cytosol18.711.12No -
C’ GFP library in Starvation Media

cytosol15.340.91No -
C’ GFP library on the background of Pup2-DaMP

below threshold -
C’ GFP library on the background of CCT mutant

below threshold17.25981.03367No
